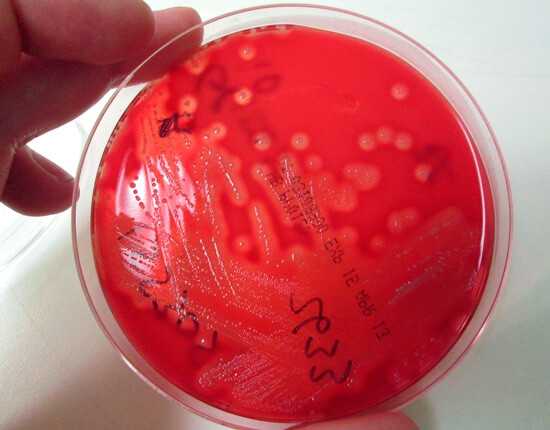

Чем и как промывать нос в домашних условиях?
В том случае если выполнять промывающие процедуры, они помогут избавиться от регулярных простудных заболеваний и станут отличным методом профилактики серьезных недугов. Соблюдение ежедневной гигиены носа позволит избавиться от его заложенности, которая с возрастом может стать нормой. А соблюдение гигиены горла и ушей станет профилактикой от кашля, охриплости и вернет острый слух. О том, чем и как промывать нос, расскажем в нашей статье.

Верхние дыхательные пути и их гигиена
Гигиене дыхательных путей отведено значительное место в текстах древней традиционной системы индийской медицины, которые были задокументированы 5 тыс. лет назад. Процедура орошения носоглотки, к примеру, служит частью учения йоги. Этот процесс рассматривают в качестве процедуры, которая очищает тело и упорядочивает мысли.
В западном мире подобные процедуры, связанные с промыванием ушей, горла и носа называют ирригационной терапией. Для того чтобы понимать цель и механизм данного лечения, следует иметь представление о строении нашей головы.
Как промыть нос ребенку, родители многие не знают.
Нос и его глубины
Носовая полость наряду с пазухами и носоглоткой покрыта слизистой оболочкой, выполняющей крайне важную роль в жизни всего человеческого организма. Она содержит в себе специальные клетки, обладающие особыми волосками или ресничками. Все эти волоски создают некое биение. Подобный механизм формирует дренаж из пазух, благодаря чему выводится образующаяся там слизь. В норме слизь у человека вырабатывается регулярно, а ее выведение происходит практически незаметно.
Каким образом болеет нос? Как правило, это происходит из-за того, что иногда на слизистую носа попадает вирус, в результате чего она воспаляется. Далее она набухает, после чего начинается отек, а продуцирование слизи в несколько раз увеличивается. Именно по этой причине, заболев отоларингологическим недугом, мы начинаем чувствовать заложенность носа, возникает необходимость в использовании платка и развивается ринит. На данном этапе нужно приготовить раствор и промыть нос.
В том случае если ринит успешно миновал и пропал вместе с температурой, а, кроме того, слабостью и недомоганием, можно считать, что человеку повезло и болезнь не окажется затянутой. Но в том случае, если недуг все же затягивается, имеются все шансы, что разовьется синусит. Синусит является процессом, как правило, гнойным, возникающим из-за отека. Протоки закрываются посредством разбухшей слизистой. На фоне всего этого в пазухах слизь застаивается и нагнаивается.
В момент, когда слизь заполнит всю пазуху, человек начнет ощущать в этом районе боль и дискомфорт. В этом случае уже стоит говорить о таких заболеваниях, как гайморит или фронтит. Гайморит локализуется в пазухах, которые расположены слева и справа от носа. Фронтит формируется во фронтальных пазухах, которые находятся над носом. Но как промывать нос, знают не все.
Нос и горло как взаимосвязанные органы
Зачастую ринит сочетается с процессом воспаления в носоглотке и глотке. Заложенность носа может дополняться болью в горле не только в покое, но и во время глотании, кроме того, может быть ощущение, как будто инородное тело присутствует в горле. Вся эта симптоматика характерна для вирусной инфекции.
По мере развития болезни воспаление может распространяться ниже глотки и доходить до гортани. Как только это происходит, начинается ларингит. Это заболевание отличается наличием охриплости и осиплости, так как воспаление протекает вблизи голосовых связок. Как только воспаление коснется связок, голос на некоторое время может пропасть полностью.
Поэтому так важно понимать, как промыть нос в домашних условиях.
Связь носоглотки с ухом
Ухо связывается с носоглоткой посредством небольшого канала, который называют слуховой трубой. Данное образование требуется для того, чтобы удавалось сбалансировать давление, которое оказывается на барабанную перепонку со стороны носовой полости. Такое строение, в свою очередь, обеспечивает беспрепятственную подвижность перепонки, а кроме того, нормальный слух. Слуховую трубу также покрывает слизистая оболочка.
Когда человека одолевает ринит, отек может распространяться и на слуховую трубу. Этот орган начинает закрываться, а когда это происходит, среднее ухо попросту теряет свою способность к дренированию. Помимо этого, давление среднего уха и атмосферные показатели становятся разными. Весь этот процесс в результате приводит к развитию отита. Зачастую им болеют дети, потому что у них слуховая труба очень широкая и короткая, поэтому инфекция легко проникает в среднее ухо. Как промывать нос, мы расскажем ниже.
Профилактика лор-заболеваний
Итак, источник воспаления, то есть непосредственно вирус, который укореняется в полости носа, служит главным возбудителем отоларингологических заболеваний. В связи с этим профилактику простудных недугов следует начинать именно с промывания носа.
Целью подобного промывания является обязательное удаление налета, а кроме того, лишней слизи и гноя с поверхности оболочки. Именно представленные субстанции служат идеальной средой для дальнейшего разрастания вирусной инфекции. Информация о том, как правильно промывать нос, и ее применение на практике поможет этого избежать.

Помимо этого, промывание носа дает возможность наилучшим образом применять лекарственные средства, будь то капли, спреи или мази. Чтобы лекарственный препарат подействовал на слизистую оболочку, она обязательно должна быть очищенной. В том случае если она покрыта слизью или гноем, лекарство попадет на эти выделения, после чего вместе с ними в результате эвакуируется.
В рамках регулярного промывания значительная часть вирусных микробов, которые находятся на поверхности слизистой, будет вымываться. Но следует учитывать, что помимо всего прочего еще существуют внутриклеточные микробы, а для того чтобы их удалить, требуются антибактериальные средства, а не только промывание.
Как правильно промывать нос?
Самым простым методом промывания носа является спринцовка или обычный шприц. Как правило, в одну ноздрю вводят наконечник шприца без иглы, далее наклоняются над раковиной, после чего под давлением направляют раствор в нос. В том случае если проходимость дыхательных каналов в порядке и не нарушена, раствор будет проходить через носоглотку и выйдет через другую ноздрю. Часть введенной жидкости может выйти через рот, так как он может попасть в глотку. Такое промывание считается правильным.
Разумеется, с первого раза вряд ли получится сделать все идеально, но, научившись расслабляться, человек сможет вливать жидкость в одну ноздрю, которая ровной струей будет выливаться из другой.
Чем промывать нос?
В аптеках на сегодняшний день представлено огромное количество всевозможных препаратов, которые предназначены для промывания. Все эти лекарственные препараты, как правило, содержат изотонический раствор. Это вещество является раствором хлорида натрия, концентрация которого составляет один процент. Это разновидность физиологического раствора. Его давление равняется осмотическому показателю крови человека. Помимо всего прочего в аптеке всегда можно приобрести препараты, изготовленные на основе морской воды. Чем промывать нос при насморке?
Приготовить необходимый раствор в целях промывания всегда можно в домашних условиях. Для этого растворяют пол-ложки соли в стакане с водой. В том случае если препарат окажется слишком концентрированным, человек это быстро почувствует, так как возникнет ощущение, что слизистую будто что-то сильно щиплет. У каждого человека свой порог чувствительности. Как бы там ни было, терпеть дискомфорт нельзя, поэтому следует сделать новый, более слабый раствор. Температура выбранного раствора для проведения промывания должна быть приближена к 36,6 градуса.

В каких случаях этого делать нельзя?
При отоларингологических заболеваниях слизистая отекает, блокируя нормальное дыхание. В том случае если в подобном состоянии подать раствор в нос под давлением, можно загнать введенную жидкость в среднее ухо. При этом вместе с жидкостью в этом направлении отправятся все опасные компоненты воспаления наряду с самим возбудителем заболевания. Поэтому, прежде чем заниматься промыванием, требуется убедиться, что нос пусть и плохо, но все же дышит. В крайней ситуации за десять минут до проведения промывания можно воспользоваться сосудосуживающими средствами.
Помимо вирусных заболеваний дыхание через нос может блокироваться за счет искривленной перегородки. В подобной ситуации эффективность промывания окажется крайне низкой. Не менее бесполезно делать промывание носа, в котором разрослись полипы. При такой патологии требуется квалифицированная хирургическая помощь.
Полоскание горла
Целью данного полоскания выступает полное удаление налета с избыточной слизью и гноем с поверхности глотки. Для того чтобы провести полоскание горла, прекрасно подойдут обычные изотонические растворы наряду с антисептическими средствами, к примеру «Фурацилин» или «Хлоргексидин». Также применяются настои таких трав, как ромашка и шалфей.
Главным условием безопасности в данном случае является то, что у человека не должно быть аллергической реакции на составляющие компоненты раствора. Вдобавок к этому антисептические растворы нежелательно проглатывать. В отношении детей, которые не в состоянии контролировать свой глотательный рефлекс, будет лучше для полоскания использовать настои трав.
Одним из наиболее распространенных растворов, отлично удаляющих бактерии с поверхности слизистой глотки, является средство, которое готовится с использованием соли и сахара. Берут две столовые ложки соли. Далее добавляют одну ложку сахара. Полученную смесь разводят в одном литре воды.
Приготовление раствора на базе морской соли
Для промывания носа часто применяют раствор морской соли. Такое средство легко приготовить и дома. Для этого требуется взять 1 ст. л. соли и растворить ее в 400 миллилитрах воды. Раствор необходимо отфильтровать.
Если в доме нет морской соли, то для того, чтобы приготовить раствор, можно использовать простую поваренную. При этом важно уделить внимание соблюдению концентрации вещества, так как при высоком содержании соли приготовленное средство способно навредить слизистой носа. Самым оптимальным считается разведение чайной ложки соли в полулитре воды.
Как промывать нос физраствором ребенку – вопрос не праздный.
Для чего это нужно?
Регулярное промывание носа в целях профилактики и лечения обладает множеством благоприятных эффектов, которые оказываются на организм. В первую очередь благодаря промыванию удается удалить вредные микрочастицы, пыль и микроорганизмы, которые населяют носовую полость. Такая процедура будет способствовать укреплению капилляров, повышая местный иммунитет. Помимо этого, промывание поможет снять отечность в районе носовой полости, что в значительной мере облегчит дыхание человека.
На фоне синуситов, гайморитов, простуд и прочих острых респираторных недугов процедура существенно сокращает срок выздоровления.
Зависит это и от того, чем можно промывать нос.

Промывание носа: основные техники
На сегодняшний день имеется много специальных устройств, которые служат для промывания носовой полости. Все эти устройства продаются в аптеках. Лучше всего для промывания подходит специальная лейка, которая по виду напоминает небольшой чайник с удлиненным горлом и маленьким носиком. Нередко для очищения применяют груши-спринцовки, но такие устройства следует использовать с особой осторожностью, иначе есть опасность травмировать носовую полость.
Промывать нос можно разными способами. Ознакомимся с наиболее распространенными и эффективными приемами:
- Человек должен встать над раковиной, наклониться и слегка повернуть голову, немного приоткрыв рот. В ноздрю, которая находится выше, вливают солевой раствор посредством специальной лейки. Таким образом попадающая жидкость сможет вытекать из другого носового прохода. При выполнении данной процедуры требуется задержать дыхание. Это крайне важно, так как иначе порции раствора смогут попадать в легкие или бронхи. Описанное промывание требуется повторить и со второй ноздрей.
- Чтобы промыть нос солью, человек должен запрокинуть голову слегка назад и немного высунуть язык. В таком положении требуется задержать дыхание, вливая солевой раствор в один из носовых проходов, после этого средство выплевывают через рот. Представленный метод промывания рекомендуется применять тогда, когда требуется очистить носоглотку.
- Следует набрать немного жидкости в ладони. Далее жидкость втягивают ноздрями, после чего выплевывают обратно через рот или нос. Описанный способ считают наиболее легким и простым.
- Как промывать нос солевым раствором? Требуется наклонить голову назад. С помощью пипетки закапывают в ноздрю раствор. Спустя тридцать секунд следует хорошо высморкаться. Данный прием промывания малоэффективен, правда, в том случае если все вышеуказанные методики для человека по каким-либо причинам окажутся неприемлемыми, лучше всего будет воспользоваться именно этим. Чаще всего этот метод промывания используют для детей.
Как промыть нос в домашних условиях, интересует многих.
Как часто следует это делать?
В целях профилактики промывание носа с использованием солевого раствора проводят до трех раз в неделю. Для проведения одного промывания достаточно будет использовать 100-150 миллилитров раствора.

В рамках лечения воспалительных отоларингологических заболеваний промывать нос требуется не реже четырех раз в сутки на протяжении двух недель. В том случае, если в наличии имеются хронические заболевания верхних дыхательных каналов в виде гайморита, ринита, тонзиллита, а кроме того, при работе в запыленном помещении промывание носа должно стать регулярной процедурой.
Теперь рассмотрим, какие средства являются наиболее эффективными для приготовления промывающих растворов.
Чем промывать нос при гайморите?
Средства для приготовления раствора
Самыми популярными и наряду с этим эффективными средствами для промывания носа, которые используются в приготовлении растворов, являются следующие компоненты:
- Сода. Данное средство прекрасно снимает отечность слизистой и обладает противовоспалительным действием, оказывает муколитический эффект. Для того чтобы добиться необходимой концентрации, берут пол чайной ложки соды и растворяют ее в стакане воды.
- Пищевая соль. Кроме соды для промывания врачи также рекомендуют использование обыкновенной соли. Как правило, берут чайную ложку и разводят ее в литре воды. Также можно приобрести физиологический солевой раствор, продающийся в любой аптеке.
- Морская соль. Особо высокой эффективностью в борьбе с гайморитом обладают готовые растворы на основе морской соли. В качестве примера таких средств можно назвать «Аквамарис», и «Маример» или «Хьюмер». Их главным компонентом выступает морская вода, которую подвергли стерилизации. Эти средства можно использовать при гайморите даже для маленьких детей. Как промывать нос «Аквалором», описано в инструкции.
- Прополис. Для того чтобы приготовить такой раствор, берут полторы чайные ложки десятипроцентной настойки прополиса и добавляют щепотку-другую соли. Растворяют все эти компоненты в стакане с теплой водой.
- Соль в сочетании с содой и йодом. Достаточно сильным раствором служит комбинация всех этих компонентов. Для приготовления раствора нужно взять по половине чайной ложки каждого из этих ингредиентов и добавить несколько капель йода. Благодаря такому составу удастся снизить воспалительную реакцию, уменьшив отек слизистой. Также за счет сочетания всех этих компонентов достигается антисептический эффект, который ускоряет заживление микротрещин, избавляя от застойных слизистых или гнойных концентраций.
Можно промывать нос «Фурацилином». Одну таблетку весом 20 миллиграммов необходимо растереть в порошкообразное состояние. Полученный порошок растворяют в ста миллилитрах кипяченой воды, однако при приготовлении раствора используют теплую воду. Таблетка растворяется не так быстро, поэтому следует несколько минут подождать, пока «Фурацилин» начнет впитывать воду, а затем аккуратно размешать лекарство ложкой.

Советы по уходу за носом
Оперирующие хирурги, которые выполняют множество операций на носовой полости, после операций почти всем пациентам назначают его промывание для быстрого заживления. Специалисты считают, что эту процедуру следует проводить ежедневно подобно чистке зубов и считают эту меру обязательной процедурой и для здоровых людей в том числе. Важно, конечно, знать, как промывать нос физраствором. Это следует делать особенно, если учесть, в каких экологических условиях находится современное общество, ведь то, чем приходится дышать, особенно живя в городе, ничего, кроме вреда для органов дыхания и всего организма не приносит.
Что касается более серьезных проблем с дыхательными путями, когда они, к примеру, не ограничиваются обычным насморком, а выражаются в виде постоянной заложенности носа, храпа или стойких болевых ощущений в горле, то это означает, что пора бросать заниматься самолечением и отправляться к отоларингологу, который определит причину болезни и назначит требуемое лечение.

Как промыть нос ребенку?
При помощи советов врачей можно понять, как малышу промывать нос, причем сделать это можно даже грудничку. Взрослому ребенку покажите методику на себе, дыхание ему следует задерживать на вдохе. Грудные дети укладываются на спину, голова поворачивается набок, по две-три капли физраствора закапываются в каждую ноздрю. Затем нужно приподнять головку, дать вытечь остаткам жидкости. Можно также положить грудничка на спину, закапать соленую воду, пропитать жгутик из ваты маслом, очистить полость носа, вкручивая жгут на 2 см.
Мы рассмотрели, как правильно промывать нос.
fb.ru
Как правильно и зачем промывать нос соленой водой
Добрый день!
Вот уже и осень началась. Правда, в наших южных краях еще очень тепло, такие приятные теплые денечки стоят. Но по вечерам и ночам уже прохладно.
С началом осени, к сожалению, все чаще становятся случаи простудных заболеваний. И я хочу Вам рассказать о лучшем, на мой взгляд, средстве от насморка – промывании носа и о том, как правильно промывать нос в домашних условиях, используя соленую воду.
Я всегда только так лечу насморк буквально за два дня без применения каких либо капель. В результате промывания столько выходит слизи! Очищается нос и придаточные (гайморовы, фронтальные) пазухи. Дышать становится очень легко, кажется, что даже в голове просветлело.
Чем можно промыть нос
Для промывания носа можно использовать и специальные физрастворы. Но лучше всего промывать нос солью, растворенной в воде.
Соль можно использовать и морскую, и обычную поваренную. Морская соль, пожалуй, лучшее средство, но это не обязательное условие. Поваренная соль тоже прекрасно справляется с задачей. Вообще соль способна вылечить многие заболевания.
Какие использовать приспособления для промывания
Люди промывают нос и при помощи шприцев, спринцовок, бутылочек, специальных чайников с узким носиком. Некоторые втягивают соленую воду из ладошек. Но с этим методом я вообще не согласна, мне кажется, что полного промывания так не достичь.
Я делаю так, как когда то прочла в книге.
Много лет назад я приобрела книгу А.Н. Зубкова и А.П. Очаповского «Хатха – йога для начинающих». К этой системе образа жизни я так и не приобщилась, но вот урок по промыванию носа, напечатанный в ней, запомнила на всю жизнь.
Для процедуры промывания носа в домашних условиях я использую самый обычный заварочный чайник. Не нужен никакой специальный сосуд, и носик у чайника может быть любой толщины. Чтобы не повредить слизистую носа, на носик чайника надеваю обычную резиновую соску, которую используют для кормления детей. Такие соски всегда продаются в аптеке, а может и дома найдутся, если у вас есть маленькие дети.
На соске ножницами вырезаю маленькое отверстие диаметром 3-5 мм.
Естественно, что чайник и соска должны быть чистыми.
Как правильно промывать нос
Теперь подробнее о том, как правильно промывать нос водой.
- Наливаем в чайник два стакана (400 г) теплой воды. Температуру воды я проверяю просто пальцем, определяю, насколько температура комфортная, она должна быть приближена к температуре тела в 36-37 градусов и не должна быть ни слишком холодной, ни слишком горячей. О том, какую воду брать – кипяченую или сырую, в книге не написано. Я использую и кипяченую, и сырую фильтрованную, немного ее нагреваю.
- Насыпаем в воду 1 чайную ложку соли без горки!, размешиваем. Как я уже сказала, можно использовать морскую соль или обычную поваренную. Я использую поваренную крупного помола. Если соль мелкая, то ее нужно насыпать чуть меньше.
- По учению йоги нужно сесть на корточки перед тазиком, но я просто наклоняюсь над ванной. Держим чайник за дно, вставляем соску в одну ноздрю – ту, которая лучше дышит, например, начнем с правой.
- Теперь важно правильно найти нужное положение тела. Потихоньку, не торопясь, наклоняем голову влево, а туловище вперед. Вода начнет вытекать струйкой из левой ноздри, не попадая в рот. Если все же в рот попадает, нужно сильнее наклониться вперед, угол наклона должен составлять примерно 90 градусов. Дышать нужно ртом.
- Когда выльется примерно половина воды (я определяю интуитивно и не обязательно уж очень строго поровну), наклоняем туловище вперед и делаем несколько резких выдохов через нос. Затем поворачиваем голову влево и делаем еще несколько резких выдохов через нос.
В этот момент нельзя сморкаться — это может привести к воспалению среднего уха! - Процедуру повторяем для очищения второй ноздри.
Как часто можно промывать нос
Промывать нос можно утром и/или вечером перед сном, но не более 2-х раз в день.
При лечении насморка и других проблемах процедуру выполняем столько дней, сколько нужно для полного выздоровления, даже в течение всей жизни.
Для профилактики во время эпидемий гриппа и других вирусных заболеваний, когда вокруг болеют люди, желательно промывать нос хотя бы раз в день.
И даже при полном здоровье один раз в неделю надо делать промывание носа, так советуют йоги.
Как промывать нос: видео
Хочу предложить еще посмотреть видео о том, как промывать нос в домашних условиях.
Правда, там мужчина говорит, что эта процедура очень неприятная. Я с ним не соглашусь, ничего страшного тут нет, просто медленно нужно выбрать правильное положение головы. Если сразу не получится, не отчаивайтесь, попробуйте еще раз, потом привыкните.
Не очень удачное я все же выбрала видео, но просто другого на эту тему не нашла, а хотела показать саму процедуру промывания носа и выдыхания после него. Неудачным я считаю его в том плане, что здесь рекомендовано использовать чайник с узким носиком (я советую любой, надев на него соску), и какой то уж очень замороченный способ определения количества соли. Кроме того, этот мужчина еще и разговаривать умудряется во время промывания!
Зачем промывать нос соленой водой
Я промываю нос соленым раствором всегда для лечения насморка, для облегчения симптомов сезонной аллергии, для профилактики гриппа.
Кстати, против гриппа есть еще одно, проверенное мною, очень эффективное средство — перекись водорода. Я применяю его уже несколько лет и гриппом не болею вообще.
Но авторы книги утверждают, что промывание носа соленой водой полезно делать при острых и хронических фарингитах, гайморите, начальной форме глаукомы, при головной боли, бессоннице, сонливости и плохой памяти. Промывание носа стимулирует развитие интеллекта и даже предотвращает преждевременное выпадение волос! Оно оказывает сильное влияние на весь организм, особенно на голову.
Промывание носа нормализует носовое дыхание, поэтому оно очень ценно для здоровья всего организма.
Промывание носа соленой водой. Противопоказания и ограничения
Процедуру промывания носа нельзя применять:
- при частых носовых кровотечениях
- при отите уха
- если нос заложен полностью -т.е обе ноздри.
В этом случае, чтобы нос задышал, советую постучать пальцами руки по переносице сверху, слева и справа попеременно в течение половины минуты, сначала легко, второй раз посильнее. Мне помогает.
Или попробуйте подышать парами пихтового масла.
Детям можно промывать нос только с 3-х летнего возраста, конечно, если у них получится такая процедура.
Напоминаю, что нельзя использовать слишком холодную и слишком горячую воду, перенасыщенный солевой раствор, и нельзя сморкаться во время и после промывания носа.
Как правильно промывать нос в домашних условиях, я вам рассказала. Поверьте, ничего трудного в этом нет. С такой процедурой справится и ребенок. У вас обязательно получится!
Я Вам от души рекомендую делать такую процедуру промывания носа, которую применяю сама. Нос после нее дышит как новенький!
Дышите легко и не болейте!
Автор блога «Здоровье как усилие воли» Ольга Смирнова
Это может быть Вам полезно:
zdorovje-usilievoli.ru
Чем промывать нос при насморке в домашних условиях ребенку и взрослому

В домашних условиях при насморке нос промывают простым раствором поваренной соли в воде. Концентрация соли при этом должна быть такой, чтобы поддерживалась изотоничность раствора (далее мы поясним, что это такое и как такой концентрации добиться) — именно изотонический раствор не будет пересушивать и раздражать слизистую оболочку носа, и не приведет к её отеку.
Таким раствором промывают нос и детям, и взрослым. Будучи правильно приготовленным, солевой раствор выполнит все необходимые задачи и не причинит никакого вреда.
Единственное ограничение: промывать нос при насморке можно только ребенку старше 5 лет. Это связано с определенными сложностями технического характера, которые мы обсудим чуть ниже.
Также необходимо понимать: не столь важно, каким именно физраствором проводить процедуру. Абсолютно все (!) подобные растворы, продающиеся в аптеках, работают по одному и тому же принципу и выполняют одни и те же задачи с одинаковой эффективностью. Нет никакой разницы, промыть ли нос ребенку простой кипяченой водой с поваренной солью или дорогим средством на основе воды Адриатического моря — эффект во всех случаях будет абсолютно одинаковым.

Солевой раствор — бюджетное и эффективное средство для промывания носа.
Именно поэтому рациональные и здравомыслящие больные или родители больных детей проводят процедуру промывания носа простой водой с солью. Те, кто страдает повышенной внушаемостью со стороны рекламных материалов — используют дорогие современные средства на основе воды экзотических морей. Те же, кто больше любит лечиться, чем быть здоровыми, увлеченно варят самые разные травы, добавляя затем мумиё и эфирные масла по старинным тибетским рецептам, чтобы потом быть уверенными, что именно этот целебный отвар обеспечил им избавление от соплей.
В целом же, цели промывания носа при насморке всегда одни и те же…
Зачем вообще нужно промывать нос при насморке
Промывание носа во время насморка проводится с двумя основными целями:
- Выведение из носа избытка слизи, в которой могут скапливаться болезнетворные бактерии и которая препятствует нормальному дыханию;
- Увлажнение слизистой оболочки — в случае, если она пересыхает, нарушается её работа, перестает удаляться слизь из носа, происходит полная закупорка носовых ходов, появляются, а затем с образованием ранок растрескиваются корки.

Случай сильной заложенности носа. Носовая слизь в большом количестве стекает в носоглотку.
С обеими этими задачами справляется вода, причем вне зависимости от того, чем именно производится промывание — физраствором или содовым раствором. Именно вода увлажняет, она же выносит с собой избыток слизи.
Поваренная соль (а не какое-то иное вещество) используется в медицинском физрастворе для того, чтобы не раздражать слизистую оболочку носа.
Почему именно соленая вода, а не простая?
Вспомните физику из школьной программы: если две жидкости с разным содержанием соли разделить перегородкой, через которую проходит только жидкость, то она — жидкость — начнет двигаться через перегородку в сторону более концентрированного раствора, чтобы уравнять концентрации. При промывании носа мы имеем аналогичную систему — жидкость в слизистой оболочке носа, саму оболочку, как мембрану, и раствор для промывания.
В чистой воде соли гораздо меньше, чем в носовой слизи и в крови — потому и требуется та самая чайная ложка соли на литр чистой воды.

Осмос — это процесс односторонней диффузии через полупроницаемую мембрану частиц растворителя в сторону большей концентрации растворённого вещества. Чтобы слизистая носа не пересыхала и не отекала, важно выдерживать строго определенную концентрацию соли при приготовлении раствора.
При этом ни соль, ни вода, ни какие другие компоненты раствора не лечат насморк. Они не способны воздействовать ни на одну из причин насморка и не могут ускорить выздоровление. Даже раствор ромашки работает только за счет того, что вода из него увлажняет слизистую и смывает с неё сопли. Промывать нос следует лишь чтобы нормализовать его состояние и создать все условия для нормальной борьбы самого организма с причинами насморка.
Убивает ли соль бактерий?
Бытует мнение, что поваренная соль помогает при насморке за счет своих якобы бактерицидных свойств. Особенно известна в этом отношении морская соль — сегодня постоянно рекламируют растворы соли Мертвого, Красного, Карибского и других морей. В доказательство приводят даже утверждение, что пропитанные солью рыба и мясо не портятся на открытом воздухе. Здесь нужно понимать, что соленую рыбу бактерии не могут повреждать из-за слишком высокой концентрации соли. Если тем же раствором соли, в котором вымачивают рыбу, закапать нос, то можно получить ожог, значительно более опасный, чем сам насморк. Соль с водой для промываний носа используется в такой концентрации, которая абсолютно безвредна и для организма, и для бактерий, а превышение этой концентрации при промывании носа очень опасно!

Соль Мертвого моря часто подается в рекламе как средство от ста болезней.
Очевидно, что регулярное и правильное промывание носа обеспечит относительную чистоту и проходимость носовых ходов, а с ними — более или менее нормальное дыхание. Это не будет значить, что насморк вылечен. Это будет лишь приемлемым состоянием для больного на тот срок, пока организм или другие действительно эффективные лекарства или процедуры не справятся с причинами болезни.
Колония стрептококков, иногда вызывающих ринит и насморк. Средства для промывания носа не способны уничтожить этих бактерий, находящихся в слизистой.
Как же приготовить такой раствор для промывания носа, который не будет вредно влиять на слизистую оболочку? Давайте разбираться…
Что такое изотонический раствор и как его приготовить
Промывать нос в домашних условиях всегда нужно лишь изотоническим раствором, содержание соли в котором будет примерно таким же, как и в крови.
Готовится такой раствор просто: в литре кипяченой воды растворяется одна чайная ложка поваренной соли. Простая кипяченая вода (да-да, та самая, взятая изначально из-под крана) и простая поваренная соль. Именно в такой концентрации раствор не будет раздражать слизистую оболочку и не приведет к её отеканию.
Такой раствор продается в аптеках под названиями «физиологический раствор», «изотонический раствор», «раствор NaCl, 0,9%» и другими. По большому счету, этот же раствор разливается во флаконы Хьюмер, Физиомер и продается за хорошие деньги, принося владельцам разливочных цехов сверхдоходы.

Аптечный раствор хлорида натрия имеет оптимальную концентрацию для эффективного промывания им носовой полости.
Обычная морская вода (для большинства морей) имеет примерно такую же концентрацию солей, как и кровь человека, и потому может использоваться в качестве физраствора. Однако на практике это делать опасно — на курортах в пляжной зоне вода сильно загрязнена, и заливать её в нос — значит, рисковать подцепить ещё одну болячку. В целом же, активное ныряние и плавание в море всегда происходит с попаданием воды в нос, и потому если выбирать участки пляжа с чистой водой, простых водных процедур при насморке будет достаточно для того, чтобы очень эффективно промыть нос. В домашних же условиях рациональнее, проще и дешевле заменить морскую воду подсоленной кипяченой.
Морская соль, йодированная, черная или поваренная — что лучше?
Абсолютно безразлично, какую из этих солей и в какой воде растворять. Многие уверены, что если взять непременно воду Атлантического океана, то она поможет вылечить насморк быстрее, чем вода из-под крана с добавлением соли. Другие считают, что лечение насморка морской солью будет эффективнее, чем лечение солью поваренной, кто-то использует черную соль или соль Мертвого моря. На самом же деле задача соли — только поддерживать определенное осмотическое давление, и поваренная соль с этой функцией справляется так же эффективно, как йодированная или набранная на побережье Красного моря.

Черная соль — еще один разрекламированный продукт
Правила промывания носа
Промывать нос при насморке в домашних условиях удобнее всего с помощью специального сосуда с узким горлышком или медицинской груши. В них набирается раствор, после чего:
- Больной наклоняется над раковиной или большим тазом;
- Поворачивает голову так, чтобы одна щека его была сверху;
- Вставляет носик сосуда или груши в верхнюю ноздрю и либо наклоняет его, если это емкость, либо аккуратно нажимает, если это груша. Вода должна затечь в верхнюю ноздрю и вытечь из нижней;
- Половина раствора выливается в одну ноздрю, после чего сосуд вынимается, голова переворачивается на другую сторону, и вся процедура повторяется;
- После промывания следует тщательно высморкаться.
Проводить такую процедуру можно сколько угодно раз (в пределах разумного) — при использовании физраствора не возникают никакие побочные эффекты, и промывание носа пойдет лишь на пользу.

Положение головы при промывании носа физраствором
Это интересно
Промывание носа практикуется йогами как ежедневная гигиеническая процедура, причем вне зависимости от наличия у них насморка. Называется она джала-нети (или яла-нети — от «jala-neti») и осуществляется с помощью специальной емкости, которую именуют нети-пот.
Видео: как йоги делают это…
Как промывать нос ребенку
Промывать нос ребенку при насморке нужно так же, как и взрослому человеку. Но сама процедура возможна только для детей старше 5 лет. Дело в том, что до этого возраста большинство детей ещё не очень уверенно управляют мышцами гортани и горла, а тот, кто промывает ему нос, может не почувствовать, когда что-то пойдет не так. В результате возможно попадание раствора в легкие, что может повлечь за собой неприятные последствия.
В отдельных случаях возможно промывание носа детям в возрасте от 3 до пяти лет, но только при одновременном соблюдении следующих условий:
- Ребенок уверенно чувствует себя в воде и умеет нырять, то есть ситуация с попаданием ему в нос воды для него привычна;
- Ребенок очень спокойный и выполняет все указания родителя, не крутит головой, не сопротивляется.
До трех лет промывать нос ребенку дома нельзя — это чревато попаданием воды с соплями и бактериями в слуховые трубы с развитием отита. Да и вообще, в этом возрасте адекватный малыш сделает все возможное, чтобы груша с раствором даже не приблизилась к его лицу.

При неправильном промывании носа у ребенка может возникнуть отит (воспалительный процесс в ухе) — так это выглядит при эндоскопии.
Главная проблема при промывании носа у ребенка — создать нужное давление раствора на входе. Если давление будет слишком большим, то малыш начнет захлебываться, либо раствор с соплями попадет в слуховые трубы. Если же давление будет недостаточным, то раствор не пройдет через нос и не промоет его.
Маленьким детям вместо промывания достаточно просто закапывать физраствор в ноздри. При избытке жидкости она будет либо вытекать с соплями наружу, либо будет стекать в горло, увлекая за собой слизь. В большинстве случаев этого вполне достаточно для увлажнения носа и удаления из него избытка слизи.
Разумеется, большинство больных и родителей больных детей не верят, что промывание носа может и должно быть таким простым. Воспитанные в обществе потребления граждане зачастую уверены — чтобы средство от насморка подействовало, оно обязательно должно быть дорогим, содержать полезные травы и производиться по современной технологии на большом заводе. По этим причинам физраствор, приготовленный дома из самых доступных компонентов, не кажется достаточно надежным, и даже он же, купленный в аптеке, не производит впечатления эффективного средства из-за своей слишком низкой цены и простого состава. А вот если купить тот же физраствор, но по цене элитной парфюмерии и с хорошей легендой, то тогда он наверняка подействует.
Другим же пациентам непременно хочется лечиться дарами природы — они верят, что чем больше в растворе будет натуральных компонентов, тем быстрее он вылечит насморк.
Специально для этих групп пациентов современная промышленность и народная медицина предлагает множество вариантов опустошить кошелек или убить несколько часов времени на приготовление чудо-отвара.

А в Китае вам могут предложить лечение насморка укусами пчел…
Специальные солевые растворы для промывания носа
Когда предприимчивые производители поняли страсть населения лечиться непременно дорогими средствами непременно в красивых флаконах, быстро было налажено производство большого числа специальных средств для промывания носа. Среди них:
- Аква Марис;
- Хьюмер;
- Аквалор;
- Долфин;
- Маример;
- Салин;
- Физиомер.

Физиомер — одно из широко разрекламированных дорогих средств для увлажнения слизистой носа.
Все они позиционируются по-разному. Особенность Аква Мариса, по утверждению производителя, заключается в использовании уникально очищенной воды Адриатического моря, набранной у побережья Хорватии. А создатели Маример заявляют, что набирают воду в Ла-Манше, куда её гонят течения Атлантического океана. Салин такой легенды не имеет, прямо намекая покупателю, что тот покупает воду с солью по цене, в десятки раз большей её себестоимости.
В любом случае, все эти препараты — это соленая вода, работающая по тому же принципу, что и копеечный физраствор. Даже если действительно для избавления от насморка промывать нос водой из Ла-Манша или из глубин Адриатического моря, сопли будут вымываться так же, как и приготовленным дома раствором.

Помогает ли сода при насморке?
Сода в качестве средства от насморка бесполезна. Кроме того, химически не очень стабильна и гидролизуется в горячей воде с выделением углекислого газа — раствор при этом становится слишком щелочным.
Так что пищевая сода не имеет никаких преимуществ перед солью при лечении насморка.
Некоторые целители рекомендуют проводить лечение содой, делая с ней ингаляции. Это совершенно бессмысленно: кроме паровых ингаляций больше никакие другие от насморка не дают эффекта, а из парового ингалятора испаряется только вода. Сода же при такой процедуре остается в самом ингаляторе (или в кастрюле, над которой производится процедура).

Пищевую соду лучше не использовать ни для промываний носа, ни для паровых ингаляций.
В любом случае, цель паровых ингаляций — увлажнить нос, и простое промывание его справится с этой задачей лучше, чем ингаляция.
Помогают ли отвары ромашки и других трав?
Некоторые травы от насморка чисто теоретически могут помочь. В частности:
- Ромашка может сработать в качестве противовоспалительного средства. Если слизистая оболочка носа сильно отекла, промывание носа ромашкой может незначительно ослабить воспаление. Рассчитывать же на полное устранение насморка здесь не стоит — средство не настолько мощное. Важно учитывать, что при введении отвара ромашки в нос возможно развитие аллергических реакций. Это особенно актуально для взрослых людей, страдающих сенной лихорадкой. Им вообще не стоит проводить лечение насморка травами, а если и начинать его — то очень осторожно, контролируя собственное состояние. И у взрослых, и у детей отвар ромашки используется путем закапывания в нос в виде капель. Ингаляции с отваром ромашки бесполезны — никакого воздействия на причины болезни и никакого терапевтического эффекта они не окажут;
Сушеные цветы ромашки
- Сок каланхоэ при насморке — оказывает выраженное раздражающее действие. Часто назначается детям для того, чтобы они прочихались — это позволяет устранить избыток соплей. Также сок каланхоэ оказывает противовоспалительное действие, однако из-за частоты побочных эффектов врачи не рекомендуют назначать его;
- Отвар коры дуба применяется так же, как и отвар ромашки.
Также иногда советуют при насморке промывать нос свекольным или морковным соком. Это абсолютно бесполезные процедуры, поскольку такие средства не обладают никакими лечебными свойствами. При этом если вода с солью помогает хотя бы за счет того, что безопасно вымывает слизь из носа, то морковный и свекольный соки при некоторых типах насморка могут даже быть опасными. В частности, если речь идет о бактериальном рините, то сахара из этих соков могут служить подкормкой для бактерий. Промыть ими носовые ходы — значит, увеличить риск развития осложнений.
В условиях клиники врач может провести промывание носа растворами антисептиков — Мирамистина, Фурацилина, Хлоргексидина. Однако такое промывание должно быть полным, охватывающим и носовые пазухи, и для его проведения должны иметься соответствующие показания (бактериальная или грибковая инфекции) и специальные инструменты. В домашних условиях такие промывания проводить нельзя.

Самостоятельное промывание носа Мирамистином в домашних условиях может привести к нежелательным последствиям.
Чем лечить насморк у детей: советы доктора
Читайте также:
antiangina.ru
Промывание носа — Лечение насморка
При возникновении отечности носа и слизистых выделениях, что свойственно для простудных и инфекционных заболеваний, рекомендуется промывать нос. Промывание носа – это комплекс гигиенических и терапевтических мероприятий с целью лечения и профилактики, который позволяет со слизистой носа убрать аллергены и слизь с микробами, пыль, уменьшает воспаление и отечность, улучшается тонус сосудов. Для более эффективного промывания необходимо использовать специальные растворы, которые обладают бактериологическими и лечебными свойствами.
Растворы
Для того чтобы победить отечность и очистить свой нос от микробов, что способствует выздоровлению и предотвращению более серьезных заболеваний, необходимо промывать нос. И от того насколько эффективным будет раствор для промывания носа будет зависеть противодействие таким заболеваниям как фронтит, ринофарингит, гайморит, вазомоторный и аллергический ринит и т.д. Наиболее популярными являются:
Долфин для промывания носа
Многие не считают нужным обращаться к врачу в случае насморка, считая, что такое заболевание не таит в себе никакой угрозы. При этом наиболее эффективным лечением считается промывание носа. Также стоит упомянуть, что многие пациенты, страдающие хроническими заболеваниями должны промывать нос регулярно. Для того чтобы сама процедура в домашних условиях несла максимальную терапевтическую пользу, некоторые фармацевтические компании занимаются разработкой комплексов для промывания носа.
Одним из самых популярных считается назальный душ Долфин, который под давлением промывает и орошает носовую полость специальным раствором. Сам назальный душ состоит из трубки, корпуса (240 мл для взрослых и 120 мл для детей) и крышки-дозатора. В комплекте с назальным душем Долфин для промывания носа идет также и аптечный раствор, всего 30 пакетов по 2 грамма в каждом. Раствор имеет состав следующий: 1,6 грамма морской соли, 0,2 грамма пищевой соли, 0,1 грамма солодки, 0,1 грамма шиповника. Для детей выпускаются пакетики, в которых находится лишь по 1 грамму такого раствора.
Но к применению такого аппарата Долфин для промывания носа есть свои противопоказания. Нельзя использовать назальный душ в случае полипов носа, при непроходимости ходов носа. Также категорически не рекомендуется использовать его больным с периодическими носовыми кровотечениями, с зло- и доброкачественными образованиями в носовой полости и придаточных пазухах. И, конечно же, при каких-либо противопоказаниях к компонентам раствора можно будет использовать лишь назальный душ.
Аквамарис (Аква Марис) для промывания носа
Аквамарис (Аква Марис) – специальное медицинское устройство, которое путем промывания носа в домашних условиях позволяет проводить лечение заболеваний слизистой оболочки, пазух, а также проводить профилактику респираторных заболеваний и гайморита. Аквамарис (Аква Марис) поставляется в комплекте с раствором на основе морской соли и натуральных веществ, которые можно применять и при беременности, и при кормлении грудью мамам. Как заявляют производители минералы и полезные вещества разжижают слизь, а селен и цинк стимулируют выработку организмом биоактивных веществ, что ускоряет лечение. Здесь нет нужды под большим напором впрыскивать раствор в нос. В данном случае раствор сам вытекает в одну ноздрю и должен вытекать из другой, очищая нос и пазухи.
Фурацилин
Фурацилин обладает отличными антибактериальными и противомикробными свойствами. Поэтому им в больницах промываются ранки, больных заставляют полоскать горло раствором фурацилина. При промывании носа данный препарат будет не менее полезен, ведь он способен победить и бактериальную инфекцию.
Промывание носа фурацилином поможет и при гайморите, и при сильном насморке (как аллергеном, так и вызванном вирусом). Для приготовления раствора необходим один стакан кипяченой теплой воды и одна таблетка, которую предварительно необходимо размельчить до состояния порошка. При сильном насморке рекомендуется вводить в каждую ноздрю по 0,5 литра раствора, который при правильном применении будет выходить через другую. Глотать раствор не рекомендуется, он предназначен исключительно для наружного применения.
Соль
Самым старым и проверенным способом, который действует безотказно в большинстве случаев, считается промывание носа солью. Для приготовления такого раствора необходима лишь морская соль. Поваренная соль не обладает такими свойствами, как морская, не содержит йод. Сам рецепт довольно прост: на один стакан (250 мл) теплой кипяченой воды необходимо взять 1-1,5 чайной ложки соли. Правда, если в доме нет морской соли, то вполне можно приготовить соленой эффективный солевой раствор из поваренной. Для этого нужно в стакане с теплой водой развести 1-1,5 чайной ложки соли, положки соды и каплю йода.
Промывание носа солью используется при воспалении придаточных пазух, отеке слизистой носа, и аденоидах у детей. Также это хорошая профилактика для здорового человека, способная предотвратить развитие аллергии и проблем с дыхательными путями.
Физраствор для промывания носа
При появлении слизи в носовой полости реснички эпителия не могут нормально функционировать, становятся как бы неподвижными. Это не позволяет организму человека самостоятельно очищаться от слизи, а соответственно избавиться от воздействия на слизистую аллергенов, бактерий и микробов. Кроме того дыхание значительно затрудняется, что вызывает определенный дискомфорт. Физраствор необходим для того чтобы разжижить слизь, и как следствие восстановить работу ресничек, что в свою очередь способствует скорейшему выздоровлению.
Его можно купить в любой аптеке или же приготовить самостоятельно. Например, самым известным домашним средством считается соляной. В аптеке на сегодняшний день продаются такие виды медикаментов, в состав которых входит физраствор:
- Капли: Но-соль, Аквалор, Отривин беби, Аква-Марис;
- Спреи: Салин, Ринолюкс, Квикс.
Правда, эти препараты стоят не дешево. Еще можно купить раствор натрия хлорида (0,9 %), который является основой для вышеупомянутых медикаментов и стоит недорого, а также сам по себе неплохо противостоит слизи в носовой полости.
Промывание носа в домашних условиях
Для того чтобы лечить некоторые несложные заболевания на подобие ринита, или для профилактики, необходимо проводить периодическое промывание носа в домашних условиях. Для начала надо определиться с веществом, которым будет промываться носовая полость. Это может быть и физраствор, и лекарство (капли, спрей). Лучше, конечно, в каждом конкретном случае попросить совета врача, особенно если речь идет о здоровье ребенка. Для домашнего промывания носа можно пользоваться как шприцем, так и всасывать раствор с ладошки носом самостоятельно. Кроме того первую подобную процедуру лучше провести в присутствии врача, который скажет, что и как надо делать правильно.
Промывание носа при гайморите
Промывания при гайморите не только не вредно, но и необходимо. Главное, чтобы процедура была проведена правильно, чтобы избежать возникновения синусита и прочих схожих заболеваний. Обязательно чтобы раствор для промывания носа был теплым. Можно набрать раствор в ладонь после чего, втянуть содержимое одной ноздрей, после чего ее зажать пальцем. Раствор должен потечь из другой ноздри. Можно попробовать шприцем под большим напором ввести лекарство в носовую полость. В больничных условиях врач предложит пройти такую процедуру, как кукушка. Что дома, что при кукушке в больнице стоит произносить звук «И», что предотвращает попаданию в глотку и в дыхательные пути жидкости. Также для лечения особо тяжелых и хронических случаев гайморита применяется прокалывание, когда в гайморовы пазухи вводятся тонкие трубочки. По этим трубочкам в пазухи вводится лекарство, которое разжижает гной. Лечение проходит стационарно.
Устройство для промывания носа
Для промывания носа можно использовать большое количество устройств, как специальных, так и не предназначенных непосредственно для этой цели. Для промывания носа можно использовать капли и спреи, продающиеся в аптеках. Они продаются во флаконах, которые имеют удобные насадки для введения в нос лекарства. Также не редкостью является специальное устройство для промывания носа, например, назальный душ Долфин или Аква Марис. В домашних условиях некоторые используют шприцы и небольшие спринцовки, позволяющие ввести в нос раствор под напором.
Кукушка
Если у человека слизь накапливается непосредственно в носовой полости, то ее весьма просто удалить. Однако, если в гайморовых пазухах скапливается гнойные массы, как при гайморите, то их необходимо их чистить. Эффективно чтобы проходила очистка гайморовых пазух от гноя, слизи и промывание носа кукушка применяется в лечебных заведениях. Кукушка, по сути, — большой пылесос для откачки слизи. Перед тем, как начать процедуру откачки через нос пациенту вводится физраствор, который растворяет гной. Затем в полость носа вводится шланг со стеклянным или пластиковым (одноразовым) наконечником. После этого начинается процесс откачки, который идет до тех пор, пока не пойдет из носа прозрачная слизь. Во время кукушки обязательно говорить «И», чтобы лекарство не пошло в горло.
Похожие статьи:
Капли для носа
Раствор для промывания носа
Ринофарингит
Не дышит нос
Воспаление слизистой носа
- < Назад
- Вперёд >
nasmork-rinit.com
Промывание носа: как правильно
Такая процедура, как промывание носа, способна избавить человека от заложенности, утреннего кашля и охриплости. Она поможет предупредить появление ринита и боли в горле. Поэтому врачи советуют промывать нос ежедневно в целях профилактики.
Чем полезна процедура?
Промывание носа и горла, другими словами, ирригационная терапия помогает предотвратить такие недуги верхних дыхательных путей, как насморк и кашель. Всем известно, что поверхность носовой полости, пазухи и носоглотки покрыта слизистой оболочкой. Благодаря тому, что она имеет волоски (реснички), вдыхаемый воздух равномерно прогревается и фильтруется.
Промывание носоглотки помогает предотвратить такие недуги:
- ОРВИ.
- ОРЗ.
- Ринит.
- Синусит.
- Гайморит.
- Фронтит.
Когда режим работы слизистой нарушается попаданием вируса или бактерий внутрь носовых каналов, последние начинают отекать, выделяя большое количество жидкости. Именно поэтому больные ОРВИ страдают от заложенности и других болезненных ощущений в области носоглотки. Воспалительный процесс носовых каналов называют ринитом. Если его не лечить, то он превратится в синусит.
Синусит ─ воспалительный процесс в пазухах носа. Зачастую он сопровождается гнойными выделениями, которые образуются из-за застоя слизи в носовой полости. Запущенная форма синусита может привести к гаймориту или фронтиту. Первая болезнь поражает гайморовы пазухи, а вторая локализуется в области переносицы.
Зачастую насморк сопровождается воспалением в области носоглотки и глотки. Кроме заложенности носа, человек ощущает дискомфорт в горле даже в состоянии покоя. Некоторых больных беспокоит чувство саднения и присутствие инородного тела в горле. Стоит знать, что эти симптомы могут являться признаками вирусной инфекции.
В тех случаях когда возбудитель заболевания опускается ниже горла, а именно в гортань, может начаться развитие ларингита. Для этого недуга характерна охриплость и осиплость, так как воспалительный процесс распространяется и на голосовые связки. Если местный иммунитет не справится с инфекцией, то больной может временно лишиться возможности воспроизводить звуки.
Нередко вирус проникает и в слуховую трубу, которая связывает ухо с носоглоткой. Ее задача в том, чтобы снижать давление на барабанную перепонку снаружи и внутри носовой полости. Таким образом она способствует свободной подвижности перепонки и нормальному слуху. Не стоит забывать, что слизистая оболочка тоже покрывает слуховую трубу изнутри.
Вернуться к оглавлению
Чем промывать носоглотку?
Современная фармакология предлагает большое количество различных медикаментов для промывания верхних дыхательных путей. Как правило, все эти лекарства имеют в своем составе изотонический (солевой) раствор. Тем не менее существуют и натуральные препараты, изготовленные на морской воде.
Но как приготовить раствор для промывания носа дома? Для этого необходимо растворить немного столовой соли в стакане теплой воды. Если во время очистки носовых путей будет ощущаться «щипание» слизистой, это означает, что жидкость получилась слишком концентрированной. Поэтому в следующий раз нужно сделать препарат немного слабее.
Но промывать нос при ОРЗ или ОРВИ, когда слизистая оболочка отекла и блокирует нормальное дыхание, нельзя, поскольку в таком состоянии раствор будет попадать в ухо, что чревато его воспалением. Кроме этого, бактерии, которые смыла жидкость, распространятся во всех дыхательных путях.
Поэтому перед процедурой промывания нужно обязательно убедиться, что нос немного дышит. Некоторые врачи советуют за несколько минут до очистки закапывать в проходы специальные сосудосуживающие медикаменты. Но это касается только тех случаев, когда инфекция находится на начальной стадии развития, а другие симптомы отсутствуют.
Перед тем как начать промывание носа и горла, необходимо убедиться в том, что у больного нет аллергии на компоненты, содержащиеся в растворе.
Нередко процесс носового дыхания блокируется не вирусным заболеванием, а искривленной перегородкой. В таком случае промывание не принесет желаемого результата. Что касается полипов в носу, то очистка каналов с помощью раствора также будет малоэффективной. Зачастую такие патологии требуют оперативного вмешательства.
Что касается полоскания горла, то оно помогает избавиться от налета, избыточной слизи или гнойных выделений, которые образовались на поверхности глотки. Для этой процедуры прекрасно подойдут обычные солевые, а также антисептические растворы. Врачи рекомендуют использовать фурацилин и хлоргексидин. Народная медицина применяет настои ромашки, шалфея и липы.
Что касается антисептических препаратов, то их ни в коем случае нельзя глотать. Детям, не умеющим удерживать жидкость во рту, лучше всего использовать травяные настойки.
Вернуться к оглавлению
Правила промывания носа
Как правильно промывать нос в домашних условиях? Одним из самых простых методов очистки верхних дыхательных путей считается ввод раствора с помощью спринцовки или обычного шприца (без иглы). Наконечник инструмента следует аккуратно вставить в ноздрю. Затем нужно медленно наклонить голову вперед (лучше это делать над раковиной) и под давлением направить раствор в нос.
В тех случаях когда носовые каналы не заложены, жидкость пройдет через носоглотку и вытечет через вторую ноздрю. Стоит учитывать тот момент, что раствор вытекает и через рот, поэтому проводить процедуру нужно очень осторожно. Иначе можно легко захлебнуться ее остатками.
У большинства людей такая техника промывания носа выходит не сразу. Но ежедневное применение этого способа поможет обрести необходимые навыки ее проведения. Перед процедурой нужно обязательно расслабиться, чтобы раствор мог легко проходить через все носовые каналы.
Таким образом промывание носа и носоглотки будет максимально эффективным. Не стоит забывать о том, что температура препарата для очистки носовых каналов должна приближаться к температуре тела — 36,6°С, так как можно обжечь слизистую.
Естественно, что промывать носовые каналы следует только взрослым, так как у детей верхние дыхательные
пути продолжают формироваться. А жидкость, введенная под сильным давлением, способна серьезно повредить слизистую оболочку. Поэтому в таком случае можно использовать чайничек, с помощью которого препарат аккуратно вливается в ноздрю.
Если человек страдает насморком, то отечность, как правило, распространяется и на вход слуховой трубы. Так как инфекция начинает постепенно ее поражать, больной может заболеть отитом среднего уха. Этот недуг приводит к временной потере слуха и болезненным ощущениям во время глотания еды. Лечение этого заболевания в запущенных формах предполагает госпитализацию. Поэтому при подобных симптомах нужно обратиться к специалисту.
Вернуться к оглавлению
Техники промывания носа дома
Существует множество способов промывания носа в домашних условиях. Первый требует использования ванной комнаты. Необходимо встать над раковиной, наклониться вперед, слегка повернуть голову в сторону и немного приоткрыть рот. В ноздрю, находящуюся выше, следует вливать солевой раствор.
Для этой цели стоит воспользоваться специальным сосудом ─ лейкой. Таким образом жидкость вытечет из другой ноздри. Эта система очистки предполагает задержки дыхания. В противном случае препарату не составит труда попасть в легкие или бронхи.
Второй способ тоже предполагает использование уборной. Для проведения процедуры нужно слегка запрокинуть назад голову и немного высунуть язык. В таком состоянии стоит задержать дыхание и ввести порцию солевого раствора в один из носовых каналов. После этого его необходимо сплюнуть ртом. Такой метод промывания следует применять для очистки носоглотки.
Третий способ считается самым быстрым и простым в применении. Нужно набрать небольшое количество раствора в ладони и резко втянуть его ноздрями. Затем нужно выплюнуть его обратно через рот или нос. С помощью этого метода можно промывать носоглотку утром перед завтраком и вечером перед сном.
Последний способ является самым неэффективным, но с его помощью можно промыть нос у ребенка. Необходимо наклонить голову назад и пипеткой закапать в ноздрю немного раствора. Спустя минуту следует хорошо высморкаться. Естественно, что этот метод промывания не гарантирует полной очистки верхних дыхательных путей. Тем не менее он хорошо подойдет для тех, кто не может воспользоваться другими методами.
Если в домашних условиях пациент не может самостоятельно промыть нос, то ему следует обратиться за помощью к врачу. Большинство лор-кабинетов оборудованы необходимыми приборами для проведения этой процедуры. Промывание носа методом перемещения предполагает использование специального аппарата ─ «кукушки».
Больной должен находиться в горизонтальном положении с немного опрокинутой назад головой. В одну ноздрю подается раствор, а в другую вставляется специальный наконечник прибора с аспиратором. Функция последнего в том, чтобы откачивать из носа использованную жидкость. Во время проведения процедуры больной обязательно должен издавать звуки кукушки, чтобы небо могло опускаться и подниматься.
Вернуться к оглавлению
Заключение по теме
Как промывать нос и как часто это нужно делать, зависит только от индивидуальных особенностей человека. Регулярное проведение процедуры защитит от воспаления проходов и пазух носа. В качестве раствора используют соль, антисептики и настои трав.
lor03.ru
Как промывать нос — Лечение насморка
Все знают, что промывание носа – это очень эффективный метод лечения и профилактики насморка. Но не все знают, как это правильно делается. Как промывать? Чем промывать? Ответы на эти и другие вопросы можно найти в данной статье.
Как правильно промывать нос?
Для того чтобы промыть нос, нужно воспользоваться простой кипячёной водой, морской водой или раствором «Долфин». Если морской воды нет, её можно сделать самостоятельно. Для этого следует взять йод, морскую соль (треть чайной ложки) и стакан воды. Вода должна быть тёплой, но не горячей. Йода следует лить всего пару капель.
Для того чтобы промыть нос, нужно купить спринцовку или устройство «Долфин». В ёмкость для промывания надо налить подготовленный раствор. После чего нужно наклониться под углом 90°и задержать дыхание. Далее необходимо к ноздре прижать конец спринцовки и нажать на неё. После того как из противоположной ноздри вытечет весь раствор, можно наполнить ёмкость для промывания и повторить процедуру. Потом нужно прикрыть рот и высморкаться. Эту процедуру можно повторить два раза.
Как промыть нос ребенку?
Дети не любят врачей, лекарства и всего того, что каким-то образом связано с лечением. Для того чтобы ребёнок согласился на процедуры, они должны напоминать игру. Для этого можно во флакон «Долфин» налить простой воды и поиграть в фонтан. Потом промыть носики игрушкам. Малыш увидит, что ничего страшного в этом нет и, возможно, будет более уступчивым.
Для того чтобы промыть нос ребёнку, надо набрать в спринцовку раствор и попросить малыша наклониться. Промывание происходит точно так же, как и у взрослых.
При высмаркивании рот ребёнка должен быть приоткрыт. Перед сном промывание лучше не делать, потому что в течение десяти минут после процедуры может вытекать вода. Зимой промывание делается за полчаса до выхода на улицу. Раствор нельзя выжимать резкими движениями, всё нужно делать плавно и аккуратно.
Нос нельзя промывать при кровотечении, непроходимости носовых ходов, аденоидах, полипах и опухолях. Для того чтобы раствор не попал в ухо, надо проводить процедуру согласно инструкции. При сильном насморке или гайморите, нос нужно промывать четыре раза в день.
Маленьким детям нельзя промывать нос. Процедура разрешена только с четырёх лет.
Как промывать нос соленой водой?
Насморк – это воспаление слизистой носа. Он может проявляться как самостоятельное недомогание или быть симптомом аллергических реакций и инфекции. Насморк возникает из-за переохлаждения. На первый взгляд насморк кажется безобидным явлением, но на самом деле он может привести к тяжёлым осложнениям.
Кто лечится лекарствами, а кому-то ближе народная медицина, которая предлагает массу способов избавления от ринита. Например, отлично справляются с недугом щелочные ингаляции. Для того чтобы их провести нужно в кипящий чайник насыпать четыре чайных ложки соды и снять его с плиты. После этого нужно наклониться над чайником, накрыть голову полотенцем и подышать десять минут. Для того чтобы не получить ожог, нужно чтобы пар не был слишком сильным и не стоит подносить близко лицо. Великолепным действием обладают ингаляции из трав, таких как мята, эвкалипт, шалфей или ромашка.
В тёплой воде можно развести половину чайной ложки обычной поваренной соли. Таким раствором можно либо промыть нос при помощи спринцовки, либо скатать ватные тампоны, намочить их и ввести в ноздри. Это способ устраняет отёки слизистой носа.
Как промывать нос при гайморите?
Для того чтобы дети и взрослые меньше болели, надо укреплять иммунитет. Большое значение имеет хорошая физическая подготовка, полноценное питание и, разумеется, закалка.
Если человек заболел гайморитом, то вылечиться можно при помощи промывания. Микроорганизмы в гайморову пазуху попадают через нос или кровь. Появляется воспаление, накапливается гной и возникает гайморит. Для того чтобы откачать гной, надо провести пункцию гайморовой пазухи, то есть сделать прокол. Если правильно и своевременно промыть нос, можно обойтись и без прокола.
Все боятся проколов, поэтому постоянно откладывают посещение и не идут к ЛОРу. Затягивание приводит к тому, что инфекция начинает распространяться и появляются осложнения. Если всё ещё не слишком запущено, промывание быстро избавит от гайморита. Иногда кроме промывания дополнительно проводят лазерную терапию, для того чтобы закрепить эффект.
Насморк опасен осложнениями, которые могут после него начаться. Поэтому нельзя относиться к нему как к чему-то простому и ничего незначащему. Нужно следить за тем, что именно выделяется из носа и отслеживать собственные ощущения. При рините жидкость прозрачная, вначале она имеет жидкую консистенцию, потом густую. Если насморк затягивается, а слизь становится зелёной и дурно пахнущей, то, возможно, уже начинается гайморит. Когда человек чихает, и него глаза краснеют, то можно смело говорить об аденовирусной инфекции. Не стоит ждать появления осложнений, ведь кроме гайморита, может ещё воспалиться внутреннее ухо. А это уже лечится намного сложнее. Если насморк длится больше недели, надо идти к врачу.
Похожие материалы:
Лечение насморка у детей
Чем лечить насморк у ребенка
Заложенность носа у ребенка
У ребенка ринит
Как лечить заложенность носа
- < Назад
- Вперёд >
nasmork-rinit.com
Чем промывать нос при насморке и как это сделать
Когда наступает период простудных заболеваний, люди начинаются интересоваться тем, чем промывать нос при насморке. Процедура промывания считается одним из самых эффективных методов лечения насморка и заложенности носовых ходов. При ежедневном проведении манипуляций это дает избежать возникновения осложнений в виде отита или синусита разной формы. Но чем лучше промывать нос при насморке детям и взрослым?
Польза промывания носовых ходов при насморке
Любой метод лечения имеет свои преимущества перед другими процедурами. Промывание оказалось не исключением. При проведении манипуляций промывание оказывает сразу несколько лечебных свойств в виде:
- удаления вязкой и густой слизи из носовых ходов. Это позволяет вместе с содержимым вывести вредные микробы со слизистой оболочки. При этом происходит нормализация работы ресничек, расположенных на эпителии;
- увлажнения пересушенной слизистой оболочки;
- восстановления дренажной функции соустьев, которые располагаются между околоносовыми пазухами и носовыми ходами;
- улучшения самочувствия и общего тонуса организма при ежедневном проведении данных манипуляций. Вследствие этого к тканям поступает больше кислорода, а также происходит улучшение кровотока;
- предотвращения размножения бактерий и микробов в носовой и ротовой полости. Достаточно промывание носа и полоскания горла проводить раз в неделю.
Растворы для промывания носа самостоятельного приготовления
Многие интересуются тем, чем промыть нос при насморке. Раствор для проведения процедуры можно приготовить самостоятельно в домашних условиях. Сюда можно отнести.
- Солевой раствор. Этот метод считается самым простым и распространенным среди остальных. Таким раствором можно промывать нос при насморке ребенку, взрослом и женщине в период вынашивания. Для его приготовления понадобится кружка остуженной кипяченной воды и чайная ложка морской соли. Раствор хорошенько перемешать. Промывания нужно проводить при помощи груши или шприца.
- Отвар ромашки. Ромашка при простуде оказывает антисептический, противовоспалительный и антимикробный эффект. Настои можно принимать внутрь, полоскать или промывать им горло. Ромашка быстро помогает справиться с болезнью и предотвратить развитие осложнений благодаря своим уникальным свойствам. Чтобы приготовить раствор для промывания, нужно взять ложку цветков и залить их кружкой кипяченной воды. Дать настояться в течение получаса, а потом процедить. Если родители не знают, чем промыть нос ребенку при насморке, то ромашка является прекрасным средством для таких процедур. Главное, перед проведением процедуры настой ромашки нужно разбавить водой в соотношении один к трем, так как она может вызвать дискомфортные ощущения у малыша.
Если ребенок отказывается от промывания или ему еще нет трех лет, то можно поступить по-другому. Ромашка детям капается в виде капель. В каждый носовой ход нужно капнуть по две-три капли. Подождать пять минут, а потом при мощи аспиратора отсосать слизь. Если ребенок уже постарше, то можно просто высморкаться.
- Лимонный сок. Можно промывать нос и таким способом. Для приготовления раствора необходимо выжать немного лимонного сока и разбавить его водой в соотношении один к трем. После процедуры необходимо смазать носовые ходы растительным маслом.
- Свекольный сок с медом. При запущенном насморке специалисты рекомендуют проводить промывания данным раствором. Для его приготовления нужно взять одну свеклу, промыть и очистить ее. Потом натереть на мелкой терке и при помощи марли выдавить сок. Добавить пол ложечки меда и разбавить водой в соотношении один к двум. Промывать нос таким раствором можно до трех раз в день.
- Солевой раствор с йодом. Для его приготовления нужно взять кружку воды, добавить туда ложку соли и несколько капель йода. Хорошенько перемешать. Промывать носовые ходы нужно до трех раз в день. Использовать данный раствор в детском возрасте не рекомендуется.
Применение лекарственных растворов для промывания носа при насморке
Многие родители интересуются тем, чем можно промывать нос ребенку при насморке. Этот вопрос является очень актуальным, так как слизистая оболочка малыша гораздо восприимчивее к внешним воздействиям, нежели у взрослых.
Зачастую для приготовления различных растворов для промывания врачи рекомендуют использовать физраствор. Он широко применяется в медицинской практике. Им промывают раны или вводят внутривенно при больших кровопотерях.
Приобрести раствор можно в аптечном киоске или приготовить его самостоятельно в домашних условиях. Для приготовления понадобится литр горячей воды и ложка обычной соли. Все хорошо перемешивается и процеживается. Малышам рекомендуют использовать средство в качестве капель. А через несколько минут проводится очищение носовых ходов при помощи аспиратора.
Физраствор и ромашка от насморка позволяют избавиться от простуды за три-четыре дня. При этом такой раствор не приведет к дискомфортным ощущениям, а, наоборот, окажет смягчающее действие.
Отваром ромашки в сочетании с физраствором можно проводить ингаляции при помощи небулайзера. Так компоненты еще лучше проникнут в дыхательные пути и разжижат застоявшуюся слизь. Для внутреннего избавления от микробов ромашка при простуде должна приниматься внутрь. Такой отвар очистит организм и окажет противовоспалительный эффект.
Промывание носа при насморке может проводиться при помощи аптечных средств. Сюда можно отнести АкваМарис, АкваЛор, Долфин или АкваМастер. В их состав входит обычный физраствор и морская соль.
При насморке антибактериального типа врачи советуют использовать фурацилиновый раствор. Его также можно применять взрослым, детям и женщинам в период вынашивания. Он оказывает антибактериальный эффект и позволяет вывести слизь из пазух даже при гайморите.
Для его приготовления нужно взять кружку воды и подогреть ее до сорока градусов. Тем временем необходимо растереть в порошок две таблетки Фурацилина. А потом добавить их в воду. Раствор тщательно перемешивается, а перед применением процеживается. Чтобы вылечить насморк, промывать нос фурацилиновым раствором нужно до трех раз в сутки в течение пяти дней. Если процедура проводится детям, то для раствора необходимо использовать одну таблетку.
Проведение процедуры промывания носа
Чтобы промывание носа принесло положительный эффект и не привело к осложнениям, нужно соблюдать несколько важных рекомендаций:
- стоит заранее позаботиться о том, чтобы приготовленный раствор был разогрет до сорока градусов. Если он будет холодным или горячим, то это приведет только к ухудшению состояния;
- вводить жидкость можно при помощи резиновой груши, специального чайника или шприца. Их можно приобрести в любом аптечном киоске;
- раствор нужно вводить в полость носа постепенно. Сначала струя должна быть слабой, а потом усиливать давление ее подачи;
- стоит избегать попадания жидкости в полость среднего уха. Это может привести к отиту;
- нормальный объем раствора не должен быть меньше двухсот миллилитров.
- чтобы провести правильное промывание носа, нужно занять нужное положение. Для этого следует занять место возле раковины, наклониться над ней и слегка повернуть голову в бок. При введении лекарства в один носовой ход, раствор должен выходить в другую ноздрю. По окончанию процедуры нужно хорошенько просморкаться.
Противопоказания к промывке носа
В некоторых случаях проводить промывание носа категорически запрещается. Сюда относят.
- Возникновение кровотечения из носовых ходов.
- Обострение хронических форм заболеваний и начавшийся отит.
- Наличие патологических образований в носовой полости в виде кист, полипов.
- Подозрение на наличие перфорации перепонки.
- Наличие аллергических проявлений на компоненты раствора.
Также стоит отметить, что малышам до трех лет нельзя проводить промывание носовых ходов при помощи груши или шприца. Для таких процедур продается специальный аспиратор, который помогает избавиться от слизи. Раствор также стоит капать аккуратно, чтобы он не попал в ухо. Необходимо учитывать и концентрацию лекарства. Чем младше пациент, тем концентрация должна быть ниже.
Детям постарше можно промывать нос при помощи груши. При этом голова ребенка должна быть обязательно наклонена в бок, чтобы жидкость не попала в ухо.
przab.ru